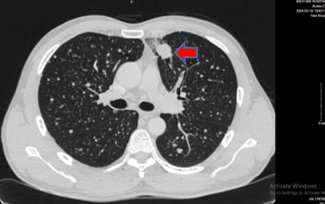

Dấu hiệu đặc biệt này khi ho giúp phát hiện ung thư phổi

Bệnh nhân nhập viện vì ho ra đờm lẫn máu. Ảnh minh họa: Freepik.
Bệnh nhân là ông N.V.C., 65 tuổi, nhập viện Trung tâm Y học hạt nhân và Ung bướu, Bệnh viện Bạch Mai, vì ho ra đờm lẫn máu.
Tại đây, kết quả chụp cắt lớp vi tính lồng ngực của ông C. phát hiện một khối đặc tròn, bờ tua gai, kích thước 28x24 mm ở thùy trên phổi trái, có hình ảnh ngấm thuốc không đồng nhất. Ngoài ra, bác sĩ còn phát hiện nhiều hạch cạnh khí quản, rốn phổi và hố thượng đòn hai bên.
Kết quả chọc hút tế bào từ hạch thượng đòn cho thấy ông mắc ung thư biểu mô di căn. Sinh thiết hạch cổ trái dưới hướng dẫn siêu âm kết luận ông mắc ung thư biểu mô tuyến có nguồn gốc từ phổi.
Bệnh nhân cho biết có nhiều năm hút thuốc lá, gia đình chưa từng phát hiện bệnh lý liên quan.
Sau đó, ông C. được chẩn đoán ung thư biểu mô tuyến thùy trên phổi trái, di căn não, gan và tuyến thượng thận, giai đoạn IV, có đột biến EGFR dương tính.
Phổi trái nhu mô ngoại vi thùy trên có khối đặc tròn bờ tua gai, kích thước 28x24 mm (mũi tên màu đỏ), ngấm thuốc không đồng nhất sau tiêm. Ảnh: BVCC.
Sau 8 tháng điều trị, sức khỏe của ông cải thiện rõ rệt. Ông hết ho khan, không còn đau ngực, khó thở, tim phổi ổn định, các cơ quan khác chưa phát hiện bất thường. Kết quả chụp cắt lớp vi tính và cộng hưởng từ cho thấy khối u phổi và các di căn giảm kích thước đáng kể.
Theo GS.TS Mai Trọng Khoa, Trung tâm Y học hạt nhân và Ung bướu, ung thư phổi hiện là loại ung thư phổ biến nhất trên thế giới, chiếm 12,4% tổng số ca mắc và 18,7% tổng số ca tử vong, theo số liệu của Globocan 2022.
Tại Việt Nam, căn bệnh này đứng thứ ba về tỷ lệ mắc (13,5%) và thứ hai về tỷ lệ tử vong (18,8%), chỉ sau ung thư gan. Nhờ các tiến bộ trong nghiên cứu sinh học phân tử, điều trị nhắm trúng đích như Osimertinib đang mở ra hy vọng mới cho bệnh nhân ung thư phổi, giúp kéo dài thời gian sống, giảm tác dụng phụ và có thể kết hợp với các phương pháp điều trị khác như hóa trị, xạ trị và phẫu thuật.
PGS.TS Phạm Cẩm Phương, Giám đốc Trung tâm Y học hạt nhân và Ung bướu, cho hay điểm đáng lo ngại là ung thư phổi ở giai đoạn đầu thường không có triệu chứng rõ ràng. Khi khối u phát triển, người bệnh có thể xuất hiện các dấu hiệu như:
Ho kéo dài trên 2 tuần, ho ra máu.
Đau tức ngực, khó thở, khàn tiếng.
Sụt cân không rõ nguyên nhân, mệt mỏi kéo dài.
Ở giai đoạn muộn: đau xương, đau đầu (nếu di căn lên não), phù vùng cổ và mặt.
Đau tức ngực, khó thở, khàn tiếng.
Sụt cân không rõ nguyên nhân, mệt mỏi kéo dài.
Ở giai đoạn muộn: đau xương, đau đầu (nếu di căn lên não), phù vùng cổ và mặt.
"Việc phát hiện sớm bệnh ở giai đoạn I (khi khối u còn nhỏ, dưới 4 cm và chưa di căn) giúp nâng tỷ lệ sống sau 5 năm lên đến 90%. Tuy nhiên, nếu phát hiện ở giai đoạn muộn (III-IV), tỷ lệ này giảm mạnh, xuống dưới 20%", PGS Phương nhấn mạnh.
Vì vậy, tầm soát định kỳ là chìa khóa trong phòng ngừa và điều trị hiệu quả ung thư phổi. Đặc biệt, với những người hút thuốc lá trên 30 năm, các khuyến cáo y tế nhấn mạnh việc chụp CT liều thấp nhằm phát hiện sớm tổn thương nhỏ từ 2-3 mm - dấu hiệu có thể chỉ ra sự hiện diện của ung thư phổi giai đoạn đầu.
Phương Anh
Nguồn Znews : https://lifestyle.znews.vn/dau-hieu-dac-biet-nay-khi-ho-giup-phat-hien-ung-thu-phoi-post1557813.html
Tin khác

9 dấu hiệu 'tố cáo' bạn có thể bị nhiễm sán dây

một giờ trước

Cảnh báo các bệnh do phế cầu khuẩn ngày càng tăng, diễn biến khó lường

một giờ trước

5 loại trái cây cực sẵn ở Việt Nam, bổ gan dưỡng thận siêu tốt lại ít người biết

17 phút trước

9 hậu quả nguy hiểm nếu để mỡ bụng tích tụ lâu ngày

một giờ trước

Nam thợ xây nguy kịch vì sốc nhiệt giữa trời nắng gắt

một giờ trước

Tăng chiều cao cho con: Những sai lầm khiến bố mẹ hối không kịp

một giờ trước